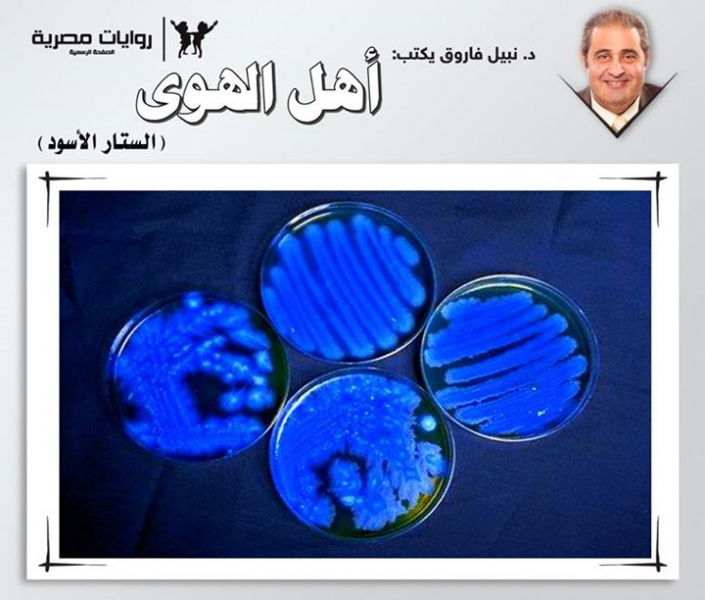

1539 مشاهدة
0
0
لا بد وأن أنتهي من كتابة هذه المذكرات بأقصى سرعة، قبل أن أعجز عن كتابتها تماما فيما بعد، لا بد وأن يعرف العالم كله الحقيقة هذا لو صدّقني أحد
لا بد وأن أنتهي من كتابة هذه المذكرات بأقصى سرعة، قبل أن أعجز عن كتابتها تماما فيما بعد..لا بد وأن يعرف العالم كله الحقيقة..
هذا لو صدّقني أحد..
ولكن كيف يصدقونني، وأنا أروي مذكراتي من داخل هذا المكان..
من المستشفى..
مستشفى الأمراض النفسية والعصبية..
أرأيتم.. أنتم أنفسكم دخلتم في زمرة غير المصدقين، أو على الأقل المتشككين، فور معرفتكم بالمكان..
ولكنني لست مريضا..
صدقوني.. لست كذلك أبدا..
كل ما في الأمر هو أن ما أرويه يبدو أشبه بالجنون، ويدفع البعض إلى الإسراع بافتراض أنني مختل عقليا، أو على الأقل نفسيا..
ولكن حتى لا نضيع الوقت في تفسيرات لا طائل منها، دعوني أقص عليكم الأمر منذ البداية.. منذ الْتقيت بمريضي عزيز..
آه.. نسيت أن أخبركم بأنني طبيب.. وطبيب أمراض نفسية وعصبية بالتحديد.. بل وصاحب نفس المستشفى، الذي يتم احتجازي فيه كمريض..
دعونا نبدأ من البداية، قبل أن يفوت الوقت.
منذ دخل عزيز عيادتي في البداية، كدت أجزم بأنه مصاب بمرض ذهاني شديد؛ إذ بدا شديد التوتر، زائغ البصر، أشعث الشعر، ثيابه غير مهندمة، ولحيته غير حليقة، حتى إنني لم أصدق ما أخبرتني به زوجته، من أنه عالم بكتيريولوجي معروف..
لم يكن عنيفا على الإطلاق، بل بدا مستسلما، بائسا، عاجزا، حتى إنني وبخلاف كل القواعد الطبية، تعاطفت معه في شدة، وتعاملت معه برفق شديد، وأنا أسأله مشفقا عما يعانيه، وما زلت أذكر إجابته العجيبة، حتى يومنا هذا:
- ما أعانيه هو صورة مما سنعانيه جميعا، في غضون عام واحد من الآن..
سألته في رفق:
- وما الذي سنعانيه جميعا؟!
تطلّع في وجهي لحظات، بعينيه الزائغتين، قبل أن يقول في يأس، وهو يشير بيده:
- سنعاني منهم.. سيسيطرون على عقولنا جميعا.. على أدمغتنا.. على إرادتنا.. لن يسلم شخص واحد منهم؛ لأنهم مثل البكتيريا.
سألته في حيرة:
- مثلها في ماذا؟!
زاغت عيناه أكثر، وهو يلوّح بذراعيه في الهواء، مجيبا:
- إنهم ينتشرون في الهواء.. لا تراهم ولا تشعر بهم، ولكنك تستنشقهم وتتنفسهم، ومن رئتيك يغزون دمك، ويسيرون عبره إلى مخك، ويبدأون السيطرة عليه.. في البداية ستسمعهم يتحدثون إليك، ثم سيلقون عليك أوامرهم، وفي خلال أسبوع واحد ستصير عبدا لهم، وستنسى حتى مَن أنت.
ثم مال نحوي، حتى شعرت بالخوف، وهو يضيف:
- ولا يوجد سبيل لمقاومتهم.. أي سبيل.
بدت لي كحالة هلوسة مثالية، ونموذج للفصام شبه الكامل، فغمغمت:
- وهل تطيع أوامرهم؟!
هزّ رأسه، قائلا في يأس:
- لن تملك سوى هذا.
تصوّرت أنني أمام حالة تستحق الدراسة بالفعل، فملت نحوه، أسأله في اهتمام:
- هل يمكنك أن تروي لي القصة من البداية؟!
تراجع في مقعده، وهو يواصل التحديق في وجهي، قبل أن يدفن وجهه بين كفيه، وهو يغمغم، وكأنه يحدّث شخصا آخر في الحجرة:
- سأخبره.. من حقه أن يعرف.. بل من حق العالم كله أن يعرف.. نعم سأخبره.
وعندما رفع عينيه إليّ، كانتا محمرتين كالدم، وهو يقول في توتر:
- البداية كانت في عينة بكتيرية جديدة، حصل عليها طبيب سموم شاب، وحار في تحديد فصيلتها، فأرسلها إلى معملي لدراستها، وإبلاغه بالنتائج.. ولقد بدأت الإجراءات الطبيعية، فوضعت جزءا من العينة في مزرعة خاصة؛ لتنمو فيها وتتكاثر؛ لدراسة سلوكها في هذا الشأن، ووضعت قطعة على شريحة مجهرية؛ لأفحصها عبر المجهر الخاص بالمعمل.
دارت عيناه في محجريهما، وهو يشير بيده، قائلا بلهجة مضطربة:
- وهنا كانت المفاجأة.
شعرت باهتمام شديد، لمعرفة تلك المفاجأة، فعدت أميل نحوه، وهو يواصل بلا انفعال:
- كانت فصيلة حيوية، لم أرَ لها مثيلا من قبل.. شكلها الخارجي يشبه البكتيريا بالفعل.. والبكتيريا العصوية لو شئت الدقة، أما سلوكها، فلم يكن سلوك بكتيريا على الإطلاق، بل كان أشبه بسلوك مستعمرات النمل، أو خلايا النحل..
بدت علىّ الحيرة، وأنا أسأله:
- وكيف هذا؟!
بدأت يداه تتحركّان في انفعال زائد، وهو يجيب:
- كلها كانت متشابهة في مظهرها الخارجي، إلا أنها انقسمت إلى مجموعات، لكل منها وظيفة محددة، والمزرعة البسيطة التي زرعتها فيها بدت بعد أسبوع واحد أشبه بمستعمرة منظمّة، بها قائد يحتل مركزها، وجنود يحيطون به، ومجموعات تنتشر في الأطراف.. مستعمرة حقيقية.
أثار الأمر اهتمامي بالفعل، وخاصة مع تلك التفاصيل الفنية، فسألته في لهفة:
- أما زالت تلك المزرعة، أو المستعمرة كما وصفتها، في معملك؟!
هزّ رأسه نفيا في أسى، وهو يجيب:
- كلا.. لقد نقلتها إلى وحدة الميكروسكوب الإلكتروني، في جامعة القاهرة، وما إن فحصتها هناك، حتى تملكني رعب حقيقي.
بدأ عرق عجيب يتصبّب على وجهه، على الرغم من برودة الجو، وزاغت عيناه في شدة، وهو يلوّح بيديه في عصبية، مكملا بكل انفعاله:
- إنها ليست بكتيريا، كما بدت تحت ميكروسكوب عادي، بل هي كائنات حية عاقلة، تختفي تحت زي خداعي، يشبه تركيب البكتيريا العصوية، كائنات ما إن أدركت أنني قد كشفت أمرها، حتى شنّت هجومها على الفور.
تراجعت في مقعدي، أتطلّع إليه لحظات في حيرة، محاولا إعادة تشخيصي الأوّلى..
الرجل، على الرغم من مظهره وعصبيته، يبدو واعيا تماما لما يقول..
وفي حياتي كلها، لم أرَ مريضا يمكنه التحّدث عن أمور علمية، بهذا القدر من الدقة والمعرفة، على الرغم من أن روايته تشبه أفلام الخيال العلمي، منها إلى الحقيقة!!.
وبكل فضولي، سألته:
- وكيف شنّت ذلك الهجوم؟!
تضاعف انفعاله، وهو يجيب:
- كنت قد اتخذت كل الاحتياطات، للحفاظ على تلك المزرعة، وعلى الرغم من هذا، فقد رأيتها تزحف على المكتب، أمام عينيّ، ثم سقطت أرضا، وتحطّمت تماما..
مال نحوي بغتة، وبدا أقرب إلى الانهيار، وهو يضيف:
- ومع تحطّمها، انطلقوا ينفّذون خطة الغزو.
غمغمت بكل دهشتي:
- غزو؟!
لوّح بذراعيه مرة أخرى، صائحا:
- لم أدرك هذا في البداية.. فقط أسرعت أجمع بقايا ذلك الطبق الزجاجي، الذي حوى المزرعة، وعندما فحصتها، لم أجد بها أي أثر لكائن واحد منها، وأدهشني أن تختفي كلها في لحظة واحدة.. ولم أدرك بالطبع أنهم في الهواء من حولي، وأنني أستنشقهم، وأطلقهم داخل جسدي، دون أن أدري.
بدأت أشعر بقلق وخوف حقيقيين، في حين نهض هو من مقعده بحركة حادة، وهو يواصل صياحه وانفعاله:
- قبل أسبوع واحد، بدأت أسمع أصواتهم داخلي، وأخبروني بكل شيء عنهم.. أخبروني بأنهم جاءوا مع نيزك صغير، سقط على الأرض، في غفلة من الزمن، وهالتهم في البداية أحجامنا الهائلة، ثم سرعان ما أدركوا أن كل ما يحرّك تلك الأجساد الضخمة، بالنسبة لهم، هو مخ صغير نسبيا.
سألته، محاولا كتمان قشعريرة سرت في جسدي:
- وكيف أدركوا هذا؟!
أشار إلى رأسه، قائلا:
- من مخي.. من ذاكرتي.. من جسدي كله... لقد علمت منهم أنني البداية، وأنهم سينتشرون في الهواء، عبر جهازي التنفسي؛ ليغوصوا في كل جسد أرضي، ويسيطرون علينا تماما.
بدأ يصرخ بكلماته، على نحو مقلق، فضغطت الزر الموجود على سطح مكتبي، وسرعان ما ظهر ممرضو المستشفى، فقلت لهم، محاولا السيطرة على انفعالاتي:
- الأستاذ عزيز يحتاج إلى راحة طويلة.. سنستضيفه لدينا لبضعة أسابيع، حتى يستردّ عافيته.
قاوم عزيز طاقم التمريض في استماتة، وهو يصرخ:
- أنت أيضا لا تصدقني.. لا أحد يصدقني.. هذا هو مكمن قوتهم.. لا أحد يقنع بوجودهم... سيسيطرون على الجميع.. أنت التالي أيها الطبيب.. أنت رسولهم التالي؛ للقضاء على إرادة البشر.
ظل يواصل صرخاته، وهم يحملونه عنوة إلى قسم الحالات العنيفة، وبكت زوجته في مرارة؛ عندما أخبرتها بأنه سيحتاج إلى علاج طويل؛ للخروج من حالة الهلوسة التي يعيش فيها..
في البداية، اضطررنا لحقنه بعقاقير مهدئة قوية، حتى تمنع إصابته بأي انهيار عصبي عنيف، وعلى الرغم مما أصابته به من استكانة، كان يحدّث نفسه طوال الوقت، باعتبار أنه يتحدث مع تلك الكائنات الميكروسكوبية، التي تعيش داخله.
ثم، وبعد يومين فحسب، صار شديد الهدوء، شارد البصر، يطيع الأوامر طاعة عمياء، دون جدل أو مناقشة..
ولكنه واصل الحديث مع نفسه..
أو معهم..
تصوّرت عندئذ أننا قد نجحنا في السيطرة على حالته، وبدأت أدوّن هذا في ملفه، حتى كانت ليلة باردة، سهرت فيها لإنهاء بعض الملفات في مكتبي، عندما بدأ الاتصال..
فجأة، سمعت صوتا من داخلي، يقول في آلية:
- فهمنا لتكوينكم يزداد يوما بعد يوم.
شعرت برعب هائل، وخيّل إلىّ أنني سأقضي نحبي رعبا؛ فالصوت كان ينبعث من أعماقي بالفعل.. من ثنايا مخي...
وبكل رعب الدنيا، صرخت:
- ماذا تريدون مني؟!
أتاني الصوت نفسه يقول:
- كل ما أردناه حصلنا عليه بالفعل.. وكل ما عليك الآن، هو أن تنقلنا إلى كل من تعرف.. عبر الهواء.
رحت أصرخ بكل قوتي:
- لا.. هذا ليس حقيقيا.. إنها هلاوس سمعية.. مجرد هلاوس سمعية.
قال ذلك الصوت بنفس الآلية:
- هذا ما سيقوله الآخرون.. وهذا يضمن عدم كشف أمرنا.. لقد أصبحت تحت سيطرتنا تقريباً.. انقلنا عبر الهواء.. انقلنا إلى كل من تعرفه.
رحت أصرخ، وأصرخ، وأصرخ، حتى امتلأ مكتبي بكل أفراد النوبة الليلية، من أطباء وطاقم تمريض..
حاولت أن أشرح لهم الأمر، إلا أن نظرات الإشفاق فاضت من عيونهم، وأسرع بعضهم يحضر العقاقير الطبية المهدّئة، و...
وأنا الآن أرقد في جناح خاص، مجاور لجناح عزيز، وقد صرت مثله، زائغ العينين، أشعث الشعر، أتلقى علاجي في انتظام، وأنا أعلم أنه في أية لحظة الآن، ستكتمل سيطرتهم على عقلي، ولن أملك إلا طاعة أوامرهم.
ولكن هذه المذكرات ستكشف أمرهم، إذا ما قرأها شخص لديه بعض الخيال..
وعندئذ ستبدأ المقاومة..
مقاومة الغزاة..
لا.. ليسوا غزاة.. إنهم السادة.. السادة الجدد..
كما تأمرون أيها السادة.. سأمزّق هذه المذكرات فورا، وسأنفّذ أوامركم، وأنقلكم عبر الهواء، لكل من ألتقي به..
أنا عبدكم المطيع أيها السادة..
مُرُوني أنفذ..
فأنتم السادة الآن..
سادتي..
وسادة الأرض..
الجدد.
نشر في 16 تموز 2019

تابع
متابع
تابع
متابع
تابع
متابع
تابع
متابع
تابع
متابع
تابع
متابع

 أديان
أديان علوم
علوم منوع
منوع ثقافة
ثقافة أدبيات
أدبيات تاريخ وجغرافيا
تاريخ وجغرافيا تقني
تقني